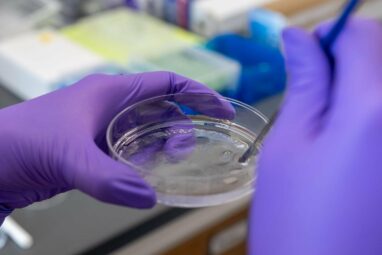

One double-helix strand of DNA could extend six feet, but it is so tightly coiled that it packs an entire...
In the world of threatened and endangered species conservation, the genomic revolution has raised some complicated questions: How can scientists...
As biologists learn more about how microbial communities work together, a major goal is understanding how their composition determines function....
Many parts of the Brazilian Amazon are neglected in ecological research, for several reasons, according to an article published in...
Salk Institute researchers, as part of a larger collaboration with research teams around the world, analyzed more than half a...
A longstanding mystery in science is how the over 85 billion individual neurons work together to form a network that...
Tropical crops such as coffee, cocoa, watermelon and mango may be at risk due to the loss of insect pollinators,...
Dynamic and changing Arctic Ocean conditions likely caused three major mortality events in the eastern North Pacific gray whale population...
The houting, a fish species that lived in North Sea estuaries and is officially extinct, turns out to be alive...
Adult insects, including butterflies and moths, typically have only three pairs of legs. But the existence of extra legs in...
Viruses are a threat to all organisms, including plants. A small group of plant stem cells, however, successfully defends itself...
A new genomic study by UCLA biologists shows that whaling in the 20th century destroyed 99% of the Eastern North...